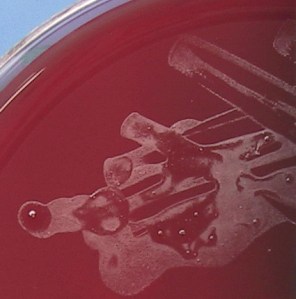
Blood agar plate showing very small microscopic whitish colonies.

Clinical Vignette 21
A middle-aged man with Type 2 diabetes mellitus and hypertension developed extensive subarachnoid haemorrhage acutely, and underwent a 4-vessel cerebral angiogram during which an anterior communicating artery aneurysm was found and coiled. He recovered gradually with inpatient rehabilitation, and was sent home after 2 weeks of hospitalisation. However, he had developed a cough with mild shortness of breath on exertion 2 days before discharge from the hospital, which worsened with subsequent development of fever, malaise and loss of appetite. He was brought back to the hospital emergency department one day after discharge and hospitalised again.
The chest X-ray and subsequent representative CT thorax images are given below, showing a massive right-sided pleural effusion that is also multi-loculated..
He had leukocytosis, and a pleural tap yielded straw-coloured fluid that was not purulent. However, both blood and pleural fluid cultures were both positive for the same organism.
Question: What was the likely organism isolated and how should the patient be managed? Note that this is actually a very rare and unusual case.
[Updated 21st February 2015]
A challenging case. This patient had Mycoplasma hominis cultured from both pleural fluid and blood cultures. Without these positive cultures, it is likely that he would not have received the appropriate therapy. As it was, he was prescribed the fluoroquinolone antibiotic levofloxacin and recovered in short order. The key issue here is that unlike other Mycoplasma spp. – especially Mycoplasma pneumoniae which is also associated with pulmonary infections – M. hominis is almost universally resistant to macrolides and the majority are also resistant to tetracyclines. An old paper published by microbiologists from the Singapore General Hospital Department of Pathology (behind the Elsevier paywall, unfortunately!) confirmed these results for isolates from Singapore.